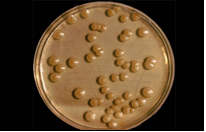

Levaduras y Mohos (Hongos): Detección y Recuento Rápido en Alimentos, Cosméticos, Superficies, Aire y Agua
Introducción
Las levaduras y los mohos forman parte del Reino Fungi, un grupo biológico esencial en la naturaleza y de gran relevancia en microbiología industrial y sanitaria. A diferencia de las plantas, los hongos no realizan fotosíntesis: obtienen su energía a partir de materia orgánica, por lo que desempeñan un papel fundamental en los ecosistemas y en la industria.
Candida albicans, levadura
oportunista en mucosas
Aunque muchas especies de hongos son beneficiosas, otras pueden causar deterioro de productos, problemas de salud o reacciones alérgicas, por lo que su detección y recuento rápido resulta clave en el control de calidad de alimentos, cosméticos, medicamentos, aguas y ambientes industriales.
1. Los Hongos y su Relación con el Ser Humano
Los hongos pueden ser unicelulares, como las levaduras, o pluricelulares y filamentosos, como los mohos.
- Levaduras: forman colonias similares a las bacterianas (ejemplo: Candida albicans, levadura oportunista en mucosas).
- Mohos: desarrollan estructuras filamentosas visibles, como Aspergillus flavus (amarillo, productor de aflatoxinas) o Aspergillus fumigatus (verde, patógeno oportunista).
Como eucariotas, los hongos se diferencian fácilmente de las bacterias: poseen núcleo, orgánulos y un tamaño celular mayor. Además, pueden crecer en medios con antibióticos como cloranfenicol u oxitetraciclina, que inhiben el crecimiento bacteriano.
2. Nichos Ecológicos y Preferencias de Crecimiento
Los hongos prefieren ambientes ácidos, mientras que las bacterias prosperan en medios neutros o alcalinos.
Esta característica se aprovecha en el diseño de medios selectivos de cultivo.
En la naturaleza, hongos y bacterias coexisten, pero el tipo de materia orgánica determina qué grupo predomina.
3. Hongos Beneficiosos y Patógenos
Mohos y levaduras beneficiosos:
- Saccharomyces cerevisiae: fermentación del pan, vino y cerveza.
- Kluyveromyces marxianus (Candida kefir): excelente probiótico simbionte humano.
- Saccharomyces boulardii: probiótico hospitalario durante tratamientos antibióticos.
- Penicillium chrysogenum: fuente del antibiótico penicilina.
- Penicillium camemberti: responsable de la corteza blanca de los quesos blandos.
Hongos y levaduras patógenos:
- Candida albicans: comensal que puede causar infecciones en situaciones de estrés o inmunodepresión.
- Aspergillus fumigatus, Alternaria alternata, Fusarium spp.: causantes de micosis, alergias y producción de micotoxinas (aflatoxinas, ocratoxinas, zearalenona, etc.).
4. Detección y Recuento: ¿Qué Exige la Legislación?
Dado que los hongos están presentes en todos los entornos, no se exige su ausencia total, sino que sus recuentos se mantengan por debajo de los límites normativos, los cuales varían según el producto:
Ámbitos de análisis más frecuentes:
- Alimentos: cereales, golosinas, frutas, harinas, miel, bollería, conservas, productos dietéticos…
- Medicamentos y cosméticos
- Aguas envasadas y refrescos
- Superficies y aire de fábricas, oficinas o entornos laborales
- Ambientes interiores con riesgo de proliferación fúngica
5. Métodos Oficiales de Detección y Recuento
En alimentos
Según la ISO 21527:2008, los medios recomendados son:
- DRBC Agar (Dichloran Rosa Bengala Cloramfenicol) para alimentos con actividad de agua > 0,95.

- Aspergillus flavus aflatoxigénico (amarillo), Aspergillus fumigatus, grave
patógeno oportunista (verde), y otros hongos y levaduras de crecimiento
lento que en otros medios no serían capaces de crecer - DG18 Agar (Dichloran Glicerol 18%) para alimentos secos.
Otros medios utilizados según el tipo de producto:
- Potato Dextrose Agar (PDA) y Malt Extract Agar: obtención de biomasa y esporulación.
- Orange Serum Agar: para zumos y conservas ácidas.
- WL Nutrient Agar o Wort Agar: para bebidas alcohólicas.
- M-Green Broth: para bebidas muy ácidas.
En cosméticos y medicamentos
Las farmacopeas siguen utilizando Sabouraud Agar, Potato Dextrose Agar y Corn Meal Agar.
Sin embargo, su lentitud hace recomendable el uso de medios más rápidos y modernos, como los desarrollados por MICROKIT.
En aguas, superficies y aire
La ISO 10012 recomienda el Rosa Bengala Agar, ampliamente usado también en control ambiental y en fábricas de piensos o alimentos.
6. Prácticas Habituales y Errores Frecuentes
- Evitar la siembra en masa: los hongos son altamente aerófilos, y esta práctica reduce su crecimiento, incluso en muchas levaduras como Candida albicans:

- Diluciones incorrectas: las esporas de mohos flotan rápidamente; si la toma de muestra se retrasa, el recuento será inexacto. Véase en la foto todas las esporas concentradas en superficie tras pocos segundos tras la agitación:

- Uso de medios bacteriológicos: muchos laboratorios aún emplean caldos sin azúcares, inadecuados para el crecimiento fúngico.
7. Innovación: Rapid YM Agar
Durante la pandemia, MICROKIT desarrolló el Rapid YM Agar, un medio cromogénico que acelera la detección y el recuento de levaduras y mohos a solo 18 horas, frente a los 3-5 días necesarios con medios convencionales.
Este avance permite a las industrias:
- Reducir tiempos de liberación de lotes.
- Mejorar la eficiencia del control microbiológico.
- Evitar pérdidas económicas derivadas de resultados lentos o imprecisos.
El Rapid YM Agar está disponible en todos los formatos: deshidratado, placas, tubos, frascos y DryPlates.
8. El Futuro de la Detección Fúngica
La tendencia en microbiología industrial es hacia métodos rápidos, precisos y respetuosos con la microbiota ambiental.
MICROKIT lidera esta evolución con medios como Rapid YM Agar, DRBC o Rosa Bengala Caf Agar, que ofrecen resultados fiables y reducen el tiempo de análisis.
Si desea esta monografía completa en PDF, con imágenes y ejemplos prácticos, puede solicitarla en:
consultastecnicas@microkit.es
Más información: https://www.microkit.es/fichas/rapid-ym-agar.pdf
No se pierda nuestro video: https://youtu.be/qE2gNZH9KWQ?si=sAKHe8KqtGkBua9V